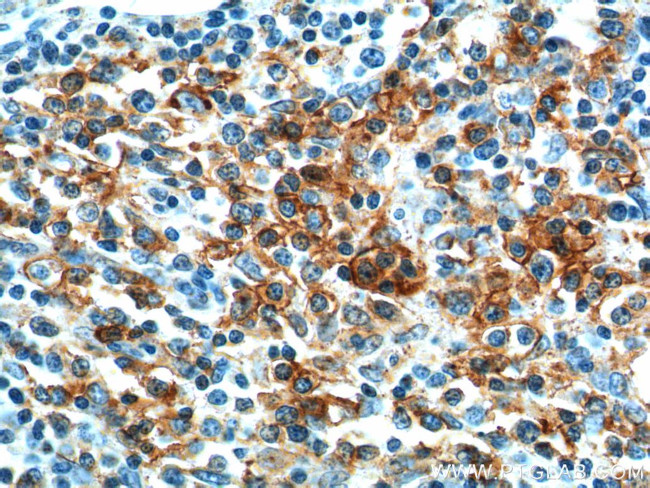
PD-1/CD279 Antibody in Immunohistochemistry (Paraffin) (IHC (P))

Search
Proteintech
PD-1/CD279 Polyclonal Antibody
{{$productOrderCtrl.translations['antibody.pdp.commerceCard.promotion.promotions']}}
{{$productOrderCtrl.translations['antibody.pdp.commerceCard.promotion.viewpromo']}}
{{$productOrderCtrl.translations['antibody.pdp.commerceCard.promotion.promocode']}}: {{promo.promoCode}} {{promo.promoTitle}} {{promo.promoDescription}}. {{$productOrderCtrl.translations['antibody.pdp.commerceCard.promotion.learnmore']}}
产品信息
18106-1-AP
种属反应
已发表种属
宿主/亚型
分类
类型
抗原
偶联物
形式
浓度
规格
纯化类型
保存液
内含物
保存条件
运输条件
产品详细信息
Immunogen sequence: MQIPQAPWP VVWAVLQLGW RPGWFLDSPD RPWNPPTFSP ALLVVTEGDN ATFTCSFSNT SESFVLNWYR MSPSNQTDKL AAFPEDRSQP GQDCRFRVTQ LPNGRDFHMS VVRARRNDSG TYLCGAISLA PKAQIKESLR AELRVTERRA EVPTAHPSPS PRPAGQFQTL VVGVVGGLLG SLVLLVWVLA VICSRAARGT IGARRTGQPL KEDPSAVPVF SVDYGELDFQ WREKTPEPPV PCVPEQTEYA TIVFPSGMGT SSPARRGSAD GPRSAQPLRP EDGHCSWPL (1-288 aa encoded by BC074740 )
靶标信息
Cell-mediated immune responses are initiated by T lymphocytes that are themselves stimulated by cognate peptides bound to MHC molecules on antig en-presenting cells (APC). T-cell activation is generally self-limited as activated T cells express receptors such as PD-1 (also known as PDCD-1) that mediate inhibitory signals from the APC. PD-1 can bind two different but related ligands, PDL-1 and PDL-2. Upon binding to either of these ligands, signals generated by PD-1 inhibit the activation of the immune response in the absence of "danger signals" such as LPS or other molecules associated with bacteria or other pathogens. Evidence for this is seen in PD1-null mice who exhibit hyperactivated immune systems and autoimmune diseases. Despite its predicted molecular weight, PD-1 often migrates at higher molecular weight in SDS-PAGE.
仅用于科研。不用于诊断过程。未经明确授权不得转售。
生物信息学
蛋白别名: CD279; CD279; PD-1; hPD1; PD-1; PD1; alternatively spliced; PDCD1; programmed cell death 1 protein; Programmed cell death protein 1; Protein PD-1; Protein PD1; sCD279; soluble CD279; systemic lupus erythematosus susceptibility 2; unnamed protein product
基因别名: AIMTBS; CD279; hPD-1; hPD-l; hSLE1; PD-1; PD1; PDCD1; SLEB2
UniProt ID: (Human) Q15116
Entrez Gene ID: (Human) 5133